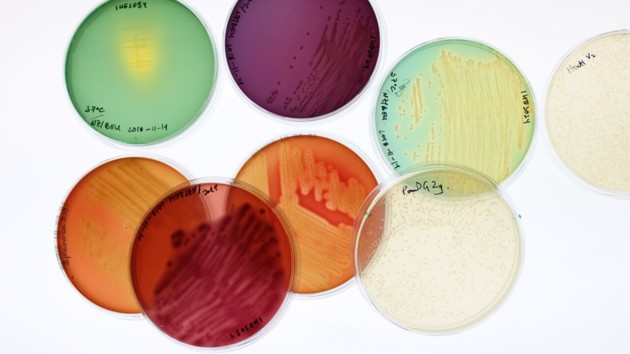

Internationella malariadagen – framstående forskning finns vid Umeå universitet
Varje år inträffar 200 miljoner nya fall av malaria, en sjukdom som kan förebyggas och behandlas. Den 25 april uppmärksammar WHO malariadagen. Forskaren Ellen Bushell och professor Oliver Billker är framstående malariaforskare vid Umeå universitet med spännande mål i sikte.
Publicerad: 2021-04-19 Uppdaterad: 2023-06-14, 08:37 Text: Ingrid Söderbergh

Oliver Billker, Professor vid Institutionen för molekylärbiologi Ellen Bushell, Forskare vid Institutionen för molekylärbiologi. Båda driver framgångsrika forskargrupper inom malariaforskning på MIMS
BildMattias PetterssonPå söndag den 25 april uppmärksammar WHO Internationella malariadagen genom att fira prestationer i länder som närmar sig – och uppnår – malariaeliminering. Malaria orsakas av Plasmodium-parasiter. Parasiterna sprids till människor genom bett av infekterade kvinnliga Anopheles-myggor, så kallade malariavektorer.
Malariaforskningen på The Laboratory of Molecular Infection Medicin Sweden, MIMS, vid Umeå universitet fokuserar på att avslöja den dolda och fascinerande biologin hos malariaparasiter och myggor, med målet att ny kunskap ska kunna nyttjas till nya läkemedel och vacciner. Duktiga malariaforskare samlas inom två olika forskargrupper.
Professor Oliver Billker: Oliver och hans forskargrupp utvecklar ny genteknik för att undersöka hur malariaparasiter reproducerar i myggor och smittas.
Dr Ellen Bushell: Ellen och hennes forskargrupp undersöker rollen av malariaparasitexporterade proteiner i värd-parasitinteraktioner.
WHO:
Läs mer om WHOs Internationella malariadag
Porträtt och film om Ellen och Oliver från Knut och Alice Wallenbergs stiftelse:
Söker nyckelgener att hindra malariesmitta
Streckkod att kartlägga proteiner och skapa vaccin mot malaria
Tema: forskning om infektionssjukdomar ska rädda miljontals liv

I kampen mot malaria – myggans immunsystem kartläggs
Upptäckten ger möjligheter att hitta sätt att förhindra mygg från att sprida malariaparasiten till människor.

Umeåforskare i vetenskapligt genombrott för malariaforskningen
Forskarteam publicerar i Cell sju metaboliska vägar som malariaparasiten behöver för att infektera levern.
Infektionsbiologi
Infektionsbiologi är ett forskningsområde där Umeå universitet ligger i framkanten.

Institutionen för molekylärbiologi
Institutionen är knuten till både teknisk-naturvetenskapliga fakulteten och medicinska fakulteten.








